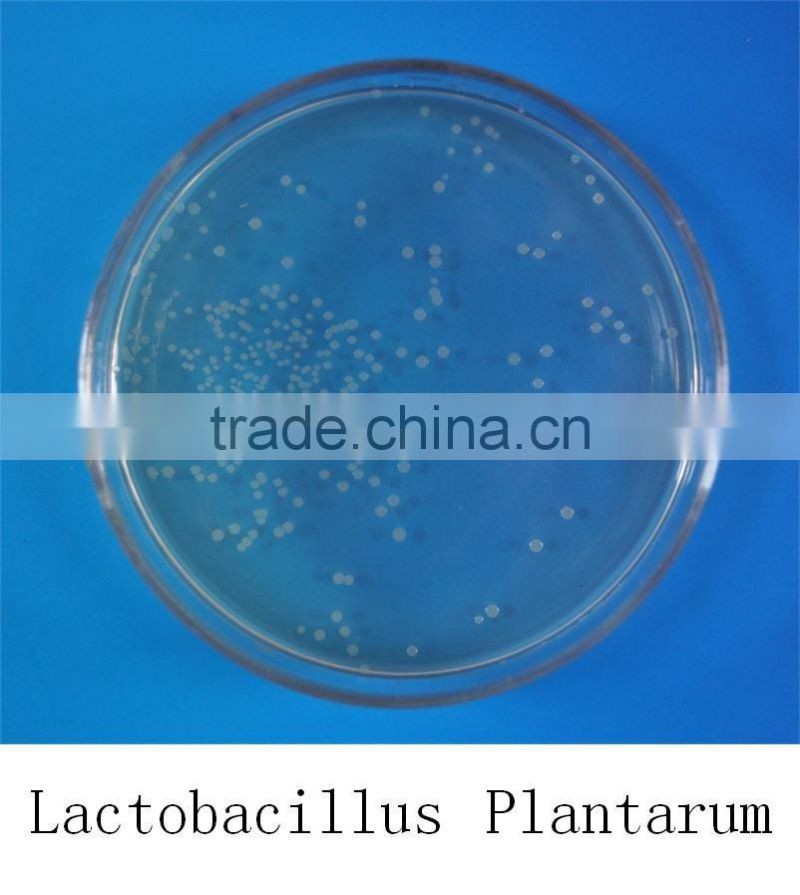
Probiotics feed additive lactobacillus plantarum

Probiotics feed additive lactobacillus plantarum
Product description
Lactobacillus plantarum

Main element:
Lactobacillus plantarum, fermentation metabolites.
Appearance:
Powder
Biological feature:
Lactobacillus plantarum is one kind of lactobacillus, the appropriate growing temperature is 30 to 35℃,anaerobic or facultative anaerobic, the strain with high activity, strong planting ability on the intestinal mucosa surface, resist the gastric acid and cholate.
Concentration:
a. Purify the pond water, especially for the pond in the middle and last period of culturing, the organic substance is too much, the pond water is black, dark brown, and old.
b. Degrade the organic substance at the bottom of the pond, deodorize,remove the algal toxin, set up a good aquatic environment.
c. Remove the ammonia and nitrite, decrease the COD and increase the oxygen, improve the water quality.
d. Regulate the balance of bacteria and algae, stable the PH value in the water body.
e. Promote the health and growth of piglet and hatchling; prevent dysentery and diarrhea, enhance anti-stress ability of postweaning piglets, significantly reduce the mortality.
f. Improve the probiotics flora in the soil, decompose the organic matter and increase the fertility of soil.
Storage:
Put it in a cool, dry and shady place.
Shelf life:
18 months.
We are manufacturer in producing probiotics for 20years, let me show you our factory.
Our south factory zone

Our north factory zone

Our production equipment

Our R&D laboratory

Our warehouse and storage

Our honours and certifications

We promise all of our products are with best quality and reasonable price
Recommended products